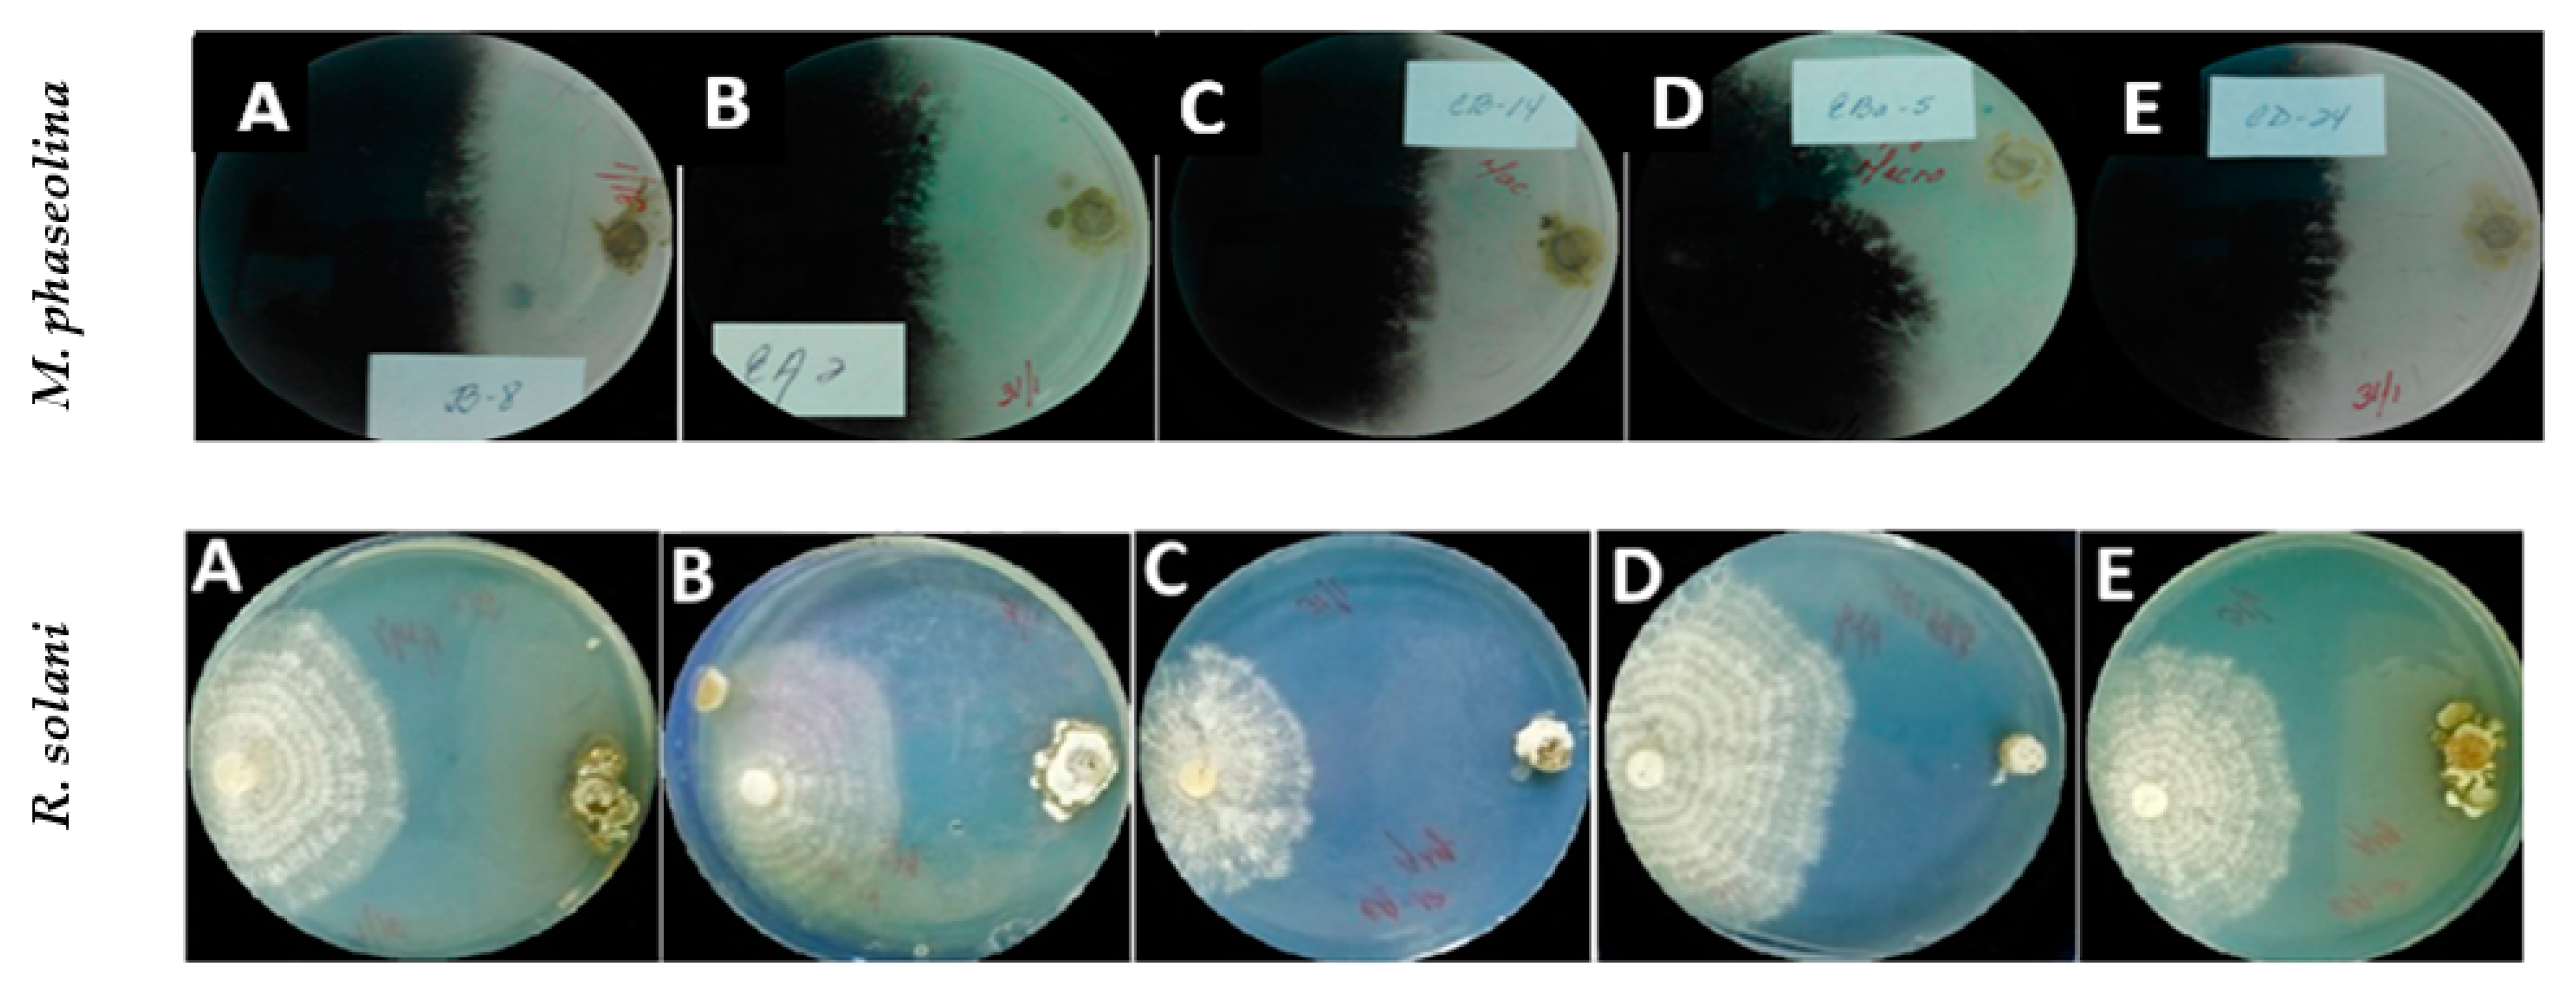
Plants 11 00645 g001 550
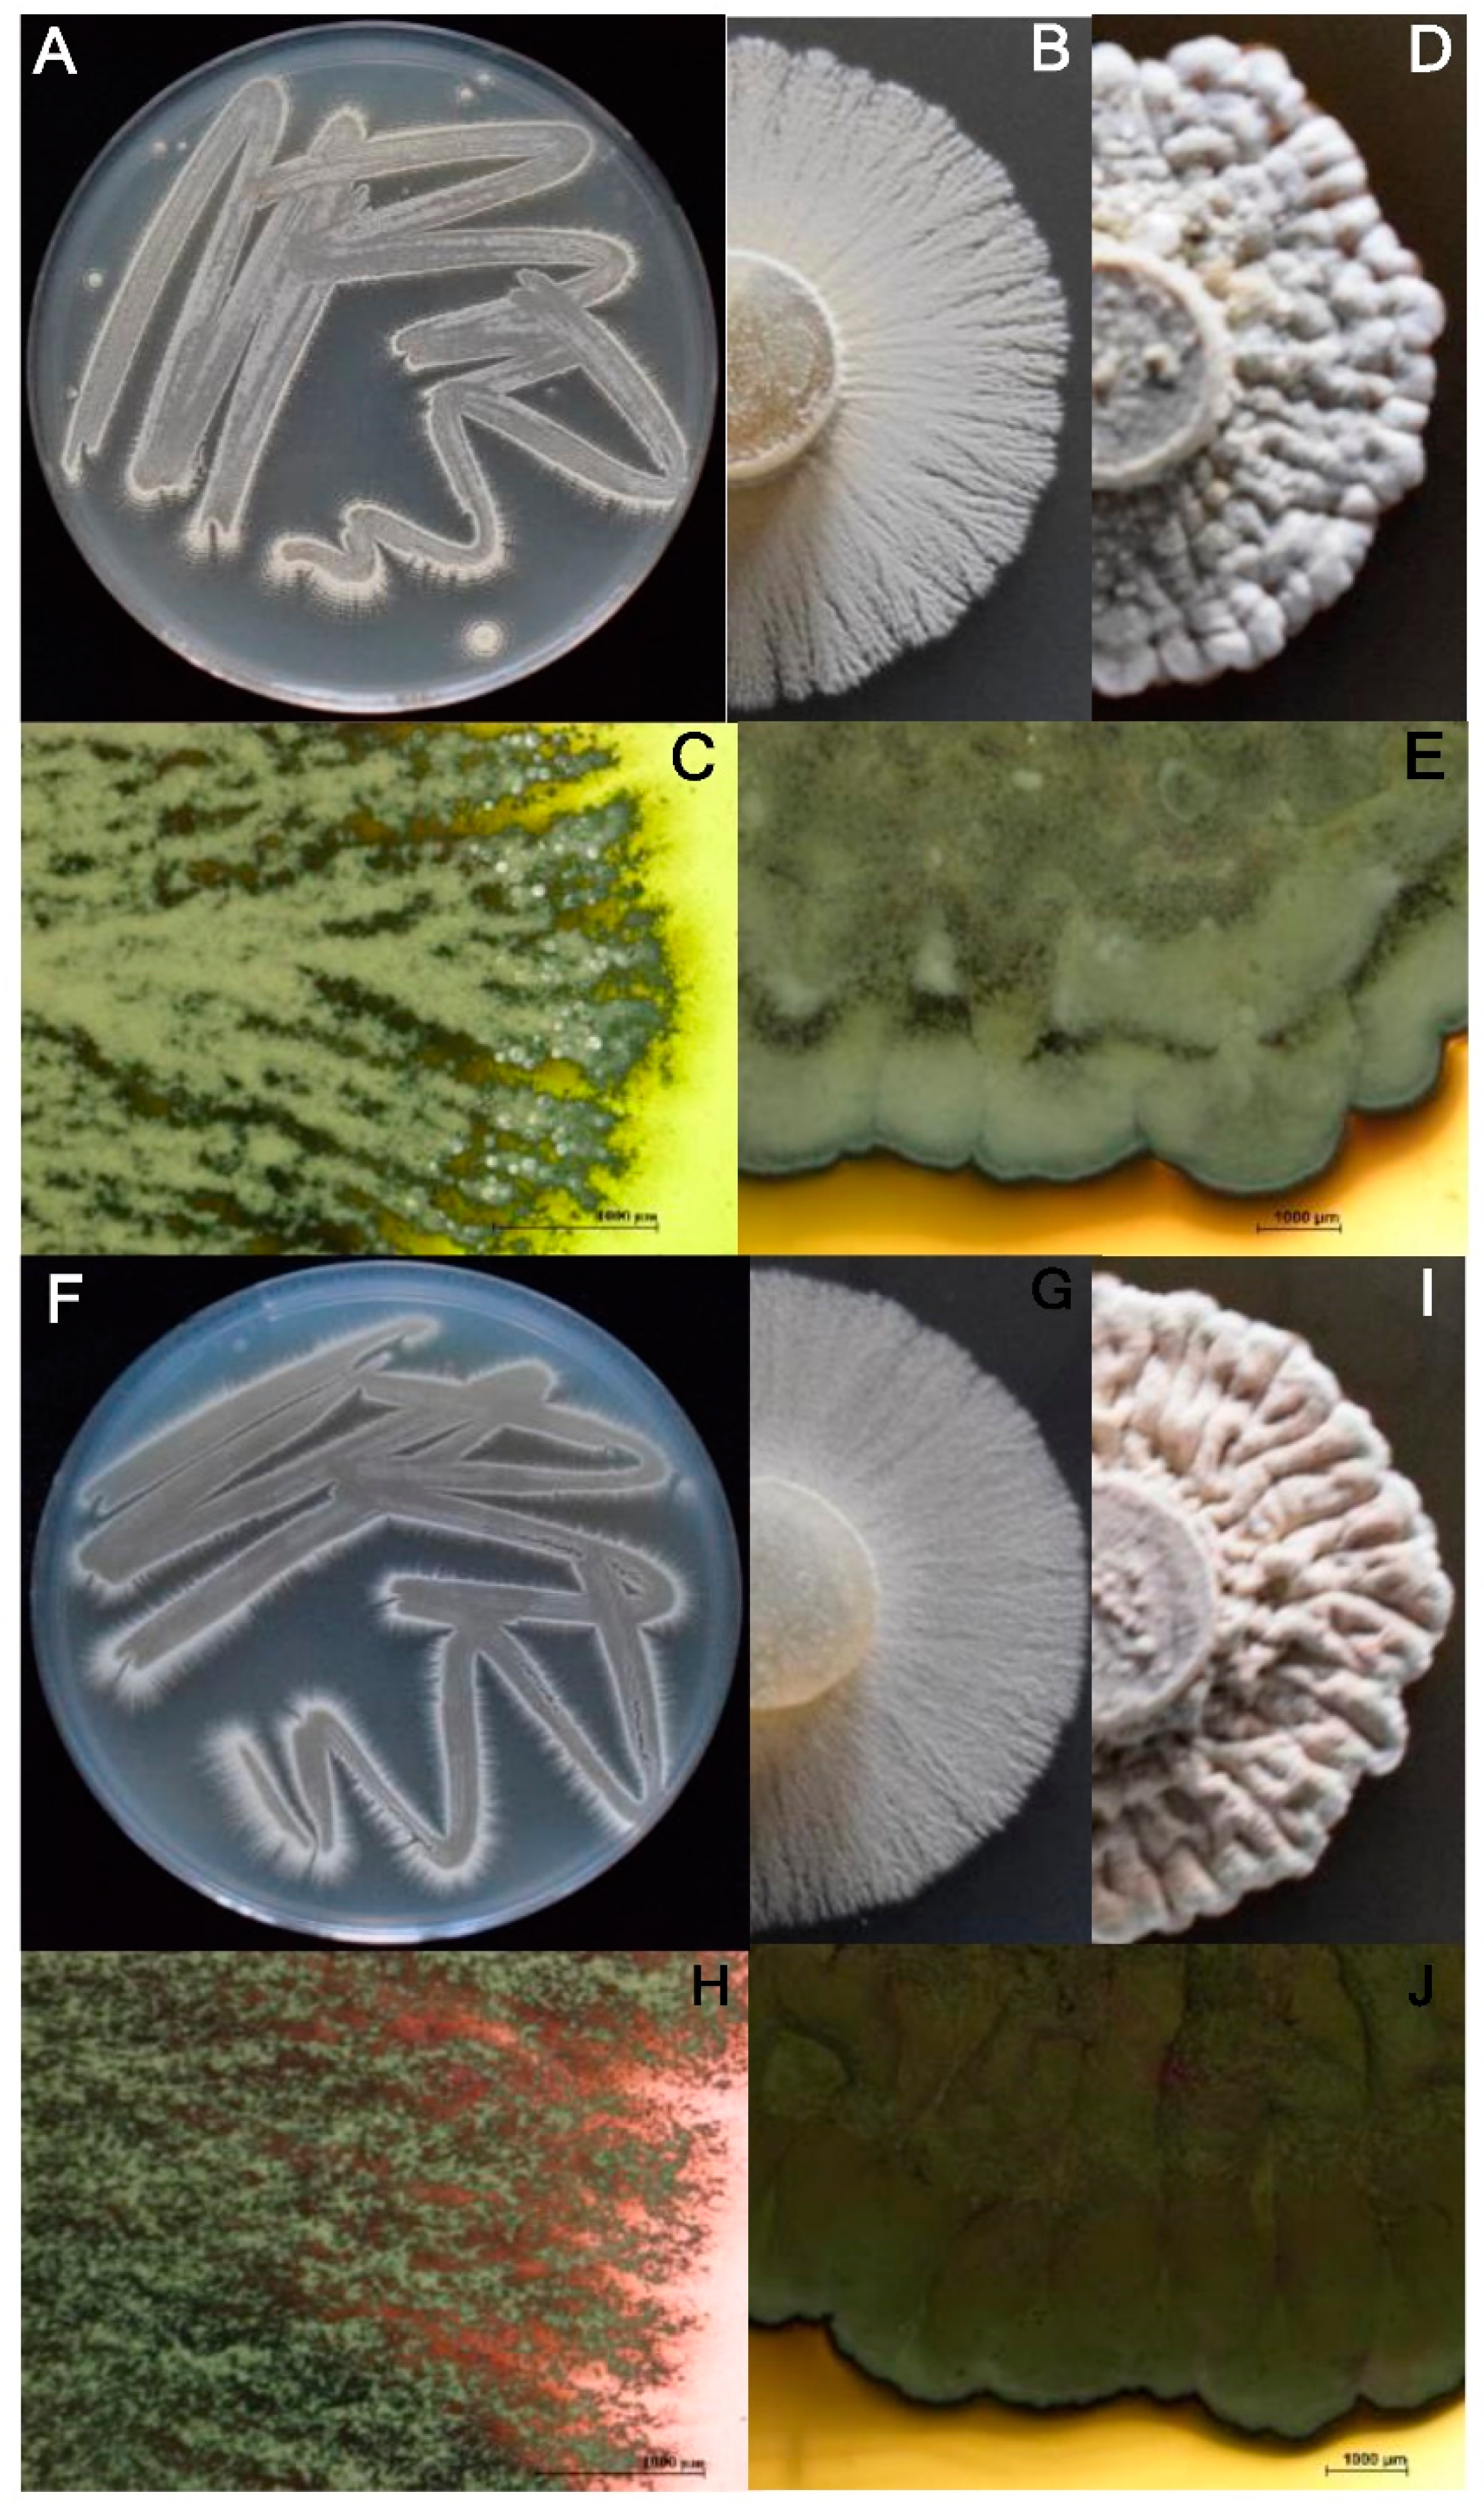
Plants 11 00645 g002 550

Characterization of Actinobacterial Strains as Potential Biocontrol Agents against Macrophomina phaseolina and Rhizoctonia solani, the Main Soil-Borne Pathogens of Phaseolus vulgaris in Cuba
Abstract
:1. Introduction
2. Results
2.1. In Vitro Effect of Actinobacterial Strains against Macrophomina phaseolina and Rhizoctonia solani: Dual Culture Assays
2.2. Qualitative Evaluation of Enzyme Activities of Actinobacterial Strains
2.3. Phenotypic Characterization
2.4. Biochemical Characterization and Assimilation of Carbon Sources
2.5. Molecular Characterization
2.6. Effect of Actinobacterial Strains against Macrophomina phaseolina and Rhizoctonia solani Infections in Planta
2.6.1. Effect of Treatments against Macrophomina phaseolina in Planta
2.6.2. Effect of Treatments against Rhizoctonia solani in Planta
3. Discussion
4. Materials and Methods
4.1. Actinobacterial Strains and Growth Conditions
4.2. In Vitro Effect of Actinobacterial Strains against Macrophomina phaseolina and Rhizoctonia solani: Dual Culture Assays
4.3. Qualitative Evaluation of Enzyme Activities of Actinobacterial Strains
4.4. Phenotypic Characterization
4.5. Biochemical Characterization and Assimilation of Carbon Sources
4.6. Molecular Characterization
4.7. Effect of Actinobacterial Strains against Macrophomina phaseolina and Rhizoctonia solani Infections in Planta
4.7.1. Plant Material
4.7.2. Biological Control Agents and Inoculum Preparation
4.7.3. Soil Inoculation with Macrophomina phaseolina and Rhizoctonia solani
4.7.4. Seed Treatments, Growth Conditions and Experimental Design
4.7.5. Disease Severity Assessment
4.8. Data Analyses
5. Conclusions
Author Contributions
Funding
Institutional Review Board Statement
Informed Consent Statement
Data Availability Statement
Acknowledgments
Conflicts of Interest
References
- Singh, G.; Dukariya, G.; Kumar, A. Distribution, Importance and Diseases of Soybean and Common Bean: A Review. Biotechnol. J. Int. 2020, 24, 86–98. [Google Scholar] [CrossRef]
- Food and Agricultural Organisation of the United Nations (FAOSTAT) Website. Available online: http://www.fao.org/faostat/es/#data/QCL/visualize (accessed on 11 August 2021).
- Ulloa, J.A.; Ulloa, P.R.; Ramírez, R.J.; Ulloa, R.B. El frijol (Phaseolus vulgaris): Su importancia nutricional y como fuente de fitoquímicos. Rev. Fuente. 2011, 3, 5–9. [Google Scholar]
- Were, S.A.; Narla, R.; Mutitu, E.W.; Muthomi, J.W.; Munyua, L.M.; Roobroeck, D.; Valauwe, B. Biochar and Vermicompost Soil Amendments Reduce Root Rot Disease of Common Bean (Phaseolous vulgaris L.). Afr. J. Biol. Sci. 2021, 3, 176–196. [Google Scholar] [CrossRef]
- González, M. Enfermedades Fungosas Del Frijol en Cuba; Técnica, C., Ed.; Científico-Técnica: La Habana, Cuba, 1988; pp. 39–60. [Google Scholar]
- Olaya, G.; Abawi, G.S. Effect of water potential on mycelial growth and on production and germination of sclerotia of Macrophomina phaseolina. Plant Dis. 1996, 80, 1347–1350. [Google Scholar] [CrossRef]
- Spedaletti, Y.; Cardenas Mercado, G.; Taboada, G.; Aban, C.; Aparicio, M.; Rodriguero, M.; Vizgarra, O.; Sühring, S.; Galíndez, G.; Galván, M. Molecular identification and pathogenicity of Rhizoctonia spp. recovered from seed and soil samples of the main bean growing area of Argentina. Aust. J. Crop Sci. 2017, 11, 952–959. [Google Scholar] [CrossRef]
- Zhao, X.; Ni, Y.; Liu, X.; Zhao, H.; Wang, J.; Chen, Y.C.; Liu, H. A simple and effective technique for production of pycnidia and pycnidiospores by Macrophomina phaseolina. Plant Dis. 2020, 104, 1183–1187. [Google Scholar] [CrossRef] [PubMed]
- Ministerio de la Agricultura (MINAG). Guía Técnica Para el Cultivo de Frijol en Cuba; Instituto de Investigaciones Hortícolas “Liliana Dimitrova”: Buenaventura, Cuba, 2008; 18p. [Google Scholar]
- González, D. Micoflora Patogénica en Semillas de Frijol (Phaseolus vulgaris) y Habichuela (Vigna Unguiculata Sesquipedalis), su Efecto en la Germinación y su Control; Trabajo de Diploma; Facultad de Ciencias Agropecuarias; UCLV: Santa Clara, Cuba, 2007; pp. 18–30. [Google Scholar]
- Abu-Tahon, M.A.; Mogazy, A.M.; Isaac, G.S. Resistance assessment and enzymatic responses of common bean (Phaseolus vulgaris L.) against Rhizoctonia solani damping-off in response to seed presoaking in Vitex agnus-castus L. oils and foliar spray with zinc oxide nanoparticles. S. Afr. J. Bot. 2022, 146, 77–89. [Google Scholar] [CrossRef]
- Muharrem, T.; Kılıçoğlu, M.Ç.; Ismail, E. Characterization and pathogenicity of Rhizoctonia isolates collected from Brassica oleracea var. acephala in Ordu, Turkey. Phytoparasitica 2020, 48, 273–286. [Google Scholar]
- Sabaté, D.C.; Petroselli, G.; Erra-Balsells, R.; Carina Audisio, M.; Brandan, C.P. Beneficial effect of Bacillus sp. P12 on soil biological activities and pathogen control in common bean. Biol. Control 2019, 141, 104–131. [Google Scholar] [CrossRef]
- Torres, M.J.; Pérez-Brandan, C.; Sabaté, D.C.; Petroselli, G.; Erra-Balsells, R.; Audisio, M.C. Biological activity of the lipopeptide-producing Bacillus amyloliquefaciens PGPBacCA1 on common bean Phaseolus vulgaris L. pathogens. Biol. Control 2016, 105, 93–99. [Google Scholar] [CrossRef]
- Mayo-Prieto, S.; Porteous-Álvarez, A.J.; Mezquita-García, S.; Rodríguez-González, Á.; Carro-Huerga, G.; del Ser-Herrero, S.; Casquero, P.A. Influence of Physicochemical Characteristics of Bean Crop Soil in Trichoderma spp. Development. Agronomy 2021, 11, 274. [Google Scholar] [CrossRef]
- Vurukonda, S.S.K.P.; Giovanadri, D.; Stefani, E. Growth Promotion and Biocontrol Activity of Endophytic Streptomyces spp. In Prime Archives in Molecular Sciences, 2nd ed.; Giampietro, L., Ed.; Vide Leaf: Hyderabad, India, 2021; 55p. [Google Scholar]
- Olanrewaju, O.S.; Babalola, O.O. Streptomyces: Implications an dinteractions in plant growth promotion. Appl. Microbiol. Biotechnol. 2019, 103, 1179–1188. [Google Scholar] [CrossRef] [PubMed] [Green Version]
- Shirling, E.T.; Gottlieb, D. Methods for characterization of Streptomyces species. Int. J. Syst. Evol. Microbiol. 1966, 16, 313–340. [Google Scholar] [CrossRef] [Green Version]
- Bergey, D.H.; Holt, J.G.; Hensyl, R. Bergey’s Manual of Determinative Bacteriology; Lippincott Williams and Wilkins: Baltimore, MD, USA, 2005; Volume 2, pp. 1208–1232. [Google Scholar]
- Ayuningrum, D.; Jati, O. Screening of actinobacteria-producing amylolytic enzyme in sediment from Litopenaeus vannamei (Boone, 1931) ponds in Rembang District, Central Java, Indonesia. Biodiversitas 2021, 22, 1819–1828. [Google Scholar] [CrossRef]
- Manigundan, K.; Joseph, J.; Ayswarya, S.; Vignesh, A.; Vijayalakshmi, G.; Soytong, K.; Radhakrishnan, M. Identification of biostimulant and microbicide compounds from Streptomyces sp. UC1A-3 for plant growth promotion and disease control. Int. J. Agric. Technol. 2020, 16, 1125–1144. [Google Scholar]
- Rani, K.; Parashar, A.; Wati, L. Estimation of hydrolyzing potential of chickpea actinomycetes for degradation of complex compounds through enzymes and acid production. Pharma. Innov. 2021, 10, 220–223. [Google Scholar]
- Liu, X.; Dou, G.; Ma, Y. Potential of endophytes from medicinal plants for biocontrol and plant growth promotion. J. Gen. Plant Pathol. 2016, 82, 165–173. [Google Scholar] [CrossRef]
- Selim, M.S.M.; Abdelhamid, S.A.; Mohamed, S.S. Secondary metabolites and biodiversity of actinomycetes. J. Genet. Eng. Biotechnol. 2021, 19, 72. [Google Scholar] [CrossRef]
- Bhatti, A.A.; Haq, S.; Bhat, R.A. Actinomycetes benefaction role in soil and plant health. Microb. Pathog. 2017, 111, 458–467. [Google Scholar] [CrossRef]
- Law, J.W.F.; Tan, K.X.; Wong, S.H.; Ab Mutalib, N.S.; Lee, L.H. Taxonomic and characterization methods of Streptomyces: A review. Prog. Microb. Mol. Biol. 2018, 1, a0000009. [Google Scholar] [CrossRef] [Green Version]
- Dalal, J.M.; Kulkarni, N.S. Antagonistic and Plant Growth Promoting Potentials of Indigenous Endophytic Actinomycetes of Soybean (Glycine max (L.) Merril). CIBTech J. Microbiol. 2014, 3, 1–12. [Google Scholar]
- Singh, C.; Parmar, R.S.; Kumar, A.; Jadon, P. Characterization of actinomycetes against phytopathogenic fungi of Glycine max (L.). Asian J. Pharm. Clin. Res. 2016, 9, 216–219. [Google Scholar]
- Fatmawati, U.; Meryandini, A.; Nawangsih, A.A.; Wahyudi, A.T. Damping-off disease reduction using actinomycetes that produce antifungal compounds with beneficial traits. J. Plant Prot. Res. 2020, 60, 233–243. [Google Scholar]
- Khendkar, A.S.; Deshpande, A.R. Isolation and screening of Streptomyces for biocontrol potential against Rhizoctonia bataticola infection of soybean. Indian J. Appl. Microbio. 2018, 21, 78–86. [Google Scholar]
- Yadav, A.K.; Yandigeri, M.; Vardhan, S.; Sivakumar, G.; Rangeshwaran, R.; Tripathi, C.P.M. Streptomyces sp. S160: A potential antagonist against chickpea charcoal root rot caused by Macrophomina phaseolina (Tassi) Goid. Ann. Microbiol. 2014, 64, 1113–1122. [Google Scholar] [CrossRef]
- Alekhya, G.; Sharma, R.; Gopalakrishnan, S. Streptomyces spp., a potential biocontrol agent of charcoal rot of sorghum caused by Macrophomina phaseolina. Indian J. Plant Prot. 2016, 44, 222–228. [Google Scholar]
- Korayem, A.S.; Abdelhafez, A.A.; Zaki, M.M.; Saleh, E.A. Biological control of green bean damping-off disease caused by Rhizoctonia solani by Streptomyces parvulus strain 10d. Egypt. J. Microbiol. 2020, 55, 87–94. [Google Scholar] [CrossRef]
- El Karkouri, A.; Assou, S.A.; El Hassouni, M. Isolation and screening of actinomycetes producing antimicrobial substances from an extreme Moroccan biotope. Pan Afr. Med. J. 2019, 33, 329. [Google Scholar] [CrossRef]
- Bernal, M.G.; Campa-Córdova, Á.I.; Saucedo, P.E.; González, M.C.; Marrero, R.M.; Mazón-Suástegui, J.M. Isolation and in vitro selection of actinomycetes strains as potential probiotics for aquaculture. Vet. World 2015, 8, 170–176. [Google Scholar] [CrossRef] [Green Version]
- Díaz, C.M. Incidence of Rhizoctonia spp., Sclerotium rolfsii and Macrophomina phaseolina on common bean in Villa Clara. Ph.D. Thesis, Universidad Central “Marta Abreu” de Las Villas, Santa Clara, Cuba, 2011. [Google Scholar]
- Sellem, I.; Triki, M.; Elleuch, L.; Cheffi, M.; Chakchouk, A.; Smaoui, S.; Mellouli, L. The use of newly isolated Streptomyces strain TN258 as potential biocontrol agent of potato tubers leak caused by Pythium ultimum. J. Basic Microbiol. 2017, 57, 393–401. [Google Scholar] [CrossRef]
- Misk, A.; Franco, C. Biocontrol of chickpea root rot using endophytic Actinobacteria. BioControl 2011, 56, 811–822. [Google Scholar] [CrossRef]
- Cuesta, G.; García-de-la-Fuente, R.; Abad, M.; Fornes, F.; Torriani-Gorini, A.; Yagil, E.; Silver, S. Isolation and identification of actinomycetes from a compost-amended soil with potential as biocontrol agents. J. Environ. Manag. 2012, 95, 281–284. [Google Scholar] [CrossRef] [PubMed]
- Kawase, T.; Saito, A.; Sato, T.; Kanai, R.; Fujii, T.; Nikaidou, N.; Miyashita, K.; Watanabe, T. Distribution and phylogenetic analysis of family 19 chitinases in Actinobacteria. Appl. Environ. Microbiol. 2004, 70, 1135–1144. [Google Scholar] [CrossRef] [Green Version]
- Meena, B.; Rajan, L.A.; Vinithkumar, N.V.; Kirubagaran, R. Novel marine actinobacteria from emerald Andaman & Nicobar Islands: A prospective source for industrial and pharmaceutical byproducts. BMC Microbiol. 2013, 13, 13–45. [Google Scholar]
- El-Sersy, N.A.; Abd-Elnaby, H.; Abou-Elela, G.M.; Ibrahim, H.A.; El-Toukhy, N.M. Optimization, economization and characterization of cellulase produced by marine Streptomyces ruber. Afr. J. Biotechnol. 2010, 9, 6355–6364. [Google Scholar]
- Ara, I.; Bukhari, N.A.; Wijayanti, D.R.; Bakir, M.A. Proteolytic activity of alkaliphilic, salt-tolerant actinomycetes from various regions in Saudi Arabia. Afr. J. Biotechnol. 2012, 11, 3849–3857. [Google Scholar]
- Franco-Correa, M. Utilización de los actinomicetos en procesos de biofertilización. Rev. Peru. Biol. 2009, 16, 239–242. [Google Scholar] [CrossRef]
- Oskay, A.M.; Üsame, T.; Cem, A. Antibacterial activity of some actinomycetes isolated from farming soils of Turkey. Afr. J. Biotechnol. 2004, 3, 441–446. [Google Scholar]
- Selvakumar, P.; Viveka, S.; Prakash, S.; Jasminebeaula, S.; Uloganathan, R. Antimicrobial activity of extracellularly synthesized silver nanoparticles from marine derived Streptomyces rochei. Int. J. Pharma Bio Sci. 2012, 3, 188–197. [Google Scholar]
- Saxena, A.; Upadhyay, R.; Kango, N. Isolation and identification of actinomycetes for production of novel extracellular glutaminase free L-asparaginase. Indian J. Exp. Biol. 2015, 53, 786–793. [Google Scholar]
- Coombs, J.T.; Franco, C.M. Isolation and identification of actinobacteria from surface-sterilized wheat roots. Appl. Environ. Microbiol. 2003, 69, 5603–5608. [Google Scholar] [CrossRef] [PubMed] [Green Version]
- Altschul, S.F.; Gish, W.; Miller, W.; Myers, E.W.; Lipman, D.J. Basic local alignment search tool. J. Mol. Biol. 1990, 215, 403–410. [Google Scholar] [CrossRef]
- Cole, J.R.; Chai, B.; Farris, R.J.; Wang, Q.; Kulam, S.A.; Mcgarrell, D.M.; Garrity, G.M.; Tiedje, J.M. The Ribosomal Database Project (RDP-II): Sequences and tools for high-throughput rRNA analysis. Nucleic Acids Res. 2005, 33, 294–296. [Google Scholar] [CrossRef] [PubMed] [Green Version]
- Ministerio de la Agricultura (MINAG). Listado oficial de Variedades Comerciales; Dirección de Semillas y Recursos Filogenéticos; CENSA: La Habana, Cuba, 2016; 41p. [Google Scholar]
- Hamdali, H.; Hafidi, M.; Virolle, M.J.; Ouhdouch, Y. Growth promotion and protection against damping-off of wheat by two rock phosphate solubilizing actinomycetes in a P-deficient soil under greenhouse conditions. Appl. Soil Ecol. 2008, 40, 510–517. [Google Scholar] [CrossRef]
- Stefanova, M.; Díaz de Villegas, M.E.; Mena, C.J. Control biológico de enfermedades de plantas en Cuba. In Control Biológico de Enfermedades de Plantas en América Latina y el Caribe; Bettiol, W., Rivera, M.C., Mondino, P., Montealegre, J.R., Colmenarez, Y.C., Eds.; Faculdad de Agronomia, Universidad de la Republica: Montevideo, Uruguay, 2014; pp. 201–204. ISBN 978-9974-0-1091-8. [Google Scholar]
- Suryawanshi, P.P.; Krishnaraj, P.U.; Suryawanshi, M.P. Evaluation of actinobacteria for biocontrol of sheath blight in rice. J. Pharmacogn. Phytochem. 2020, 9, 371–376. [Google Scholar]
- Hernández, J.A.; Pérez, J.M.; Bosch, I.D.; Rivero, S.N. Clasificación de los Suelos de Cuba; Ediciones INCA: Mayabeque, Cuba, 2015; pp. 10–75. [Google Scholar]
- Hernández Pérez, D.; Díaz Castellanos, M.; Quiñones Ramos, R.; Santos Bermúdez, R.; Portal González, N.; Herrera Isla, L. Control de Rhizoctonia solani en frijol común con rizobacterias y productos naturales. Cent. Agríc. 2018, 45, 55–60. [Google Scholar]
- Van Schoonhoven, A.; Corrales, P. Sistema Estándar Para la Evaluación de Germoplasma de Frijol; CIAT: Cali, Colombia, 1987; 56p. [Google Scholar]
- Townsend, G.R.; Heuberger, J.W. Methods for estimating losses caused by diseases in fungicide experiments. Plant Dis. Rep. 1943, 27, 340–343. [Google Scholar]
- Bradley, C.A.; Hartman, G.L.; Nelson, R.L.; Müller, D.S.; Pedersen, W.L. Response of ancestral soybean lines and comercial cultivars to Rhizoctonia solani root and hypocotyls rot. Plant Dis. 2001, 85, 1091–1095. [Google Scholar] [CrossRef] [Green Version]
- Keijer, J.; Korman, M.G.; Dullemans, A.M.; Houterman, P.M.; De Bree, J.; Van Silfhout, C.H. In vitro analysis of host plant specificity in Rhizoctonia solani. Plant Pathol. 1997, 46, 659–669. [Google Scholar] [CrossRef]
- Steel, R.G.D.; Torrie, J.H. Bioestadística: Principios y Procedimientos, 2nd ed; McGraw Hill: Bogotá, Colombia, 1985; 613p. [Google Scholar]
- Zar, J.H. Biostatistical Analysis, 5th ed.; Pte: New Delhi, India; Pearson Education: Singapore, 2010. [Google Scholar]
- Analytical Software. StatistixUser’s Manual. Analytical Software, Tallahassee, FL, USA. 2013. Available online: https://www.scribd.com/document/381816978/Statistix-10-Manual (accessed on 18 October 2021).

| Actinobacterial Strain | (MGI; %) a,b | |
|---|---|---|
| Macrophomina phaseolina | Rhizoctonia solani | |
| CBQ-CB-14 | 60.9 ± 1.63 | 69.8 ± 1.40 |
| CBQ-EA-2 | 70.4 ± 1.23 | 77.4 ± 1.20 |
| CBQ-EA-12 | 46.2 ± 1.32 | 78.3 ± 0.37 |
| CBQ-OSS-3 | 62.8 ± 1.55 | 61.2 ± 0.53 |
| CBQ-ESFe-4 | 52.0 ± 2.00 | 63.7 ± 1.19 |
| CBQ-CD-24 | 64.6 ± 1.48 | 75.4 ± 1.22 |
| CBQ-EBa-5 | 60.5 ± 1.65 | 45.9 ± 1.32 |
| CBQ-EBa-21 | 54.0 ± 1.11 | 55.7 ± 2.01 |
| CBQ-Plat-2 | 66.6 ± 0.78 | 37.3 ± 1.91 |
| CBQ-WP-14 | 56.7 ± 1.81 | 37.1 ± 0.40 |
| CBQ-B-8 | 63.1 ± 1.54 | 69.0 ± 1.63 |
| CBQ-J-4 | 28.1 ± 1.71 | 35.4 ± 2.70 |
| CBQ-CB-3 | 40.5 ± 0.91 | 40.1 ± 1.35 |
| CBQ-EA-3 | 44.4 ± 0.65 | 0.0 ± 0.00 |
| CBQ-EB-27 | 0.0 ± 0.00 | 0.0 ± 0.00 |
| CBQ-EC-3 | 32.2 ± 0.60 | 0.0 ± 0.00 |
| CBQ-EC-18 | 36.0 ± 1.30 | 54.6 ± 0.91 |
| CBQ-ECa-24 | 29.9 ± 1.51 | 0.0 ± 0.00 |
| CBQ-ESFe-5 | 31.6 ± 1.31 | 0.0 ± 0.00 |
| CBQ-ESFe-10 | 35.8 ± 1.25 | 0.0 ± 0.00 |
| CBQ-ESFe-11 | 3.24 ± 1.01 | 0.0 ± 0.00 |
| CBQ-ESFe-12 | 38.9 ± 1.32 | 43.5 ± 1.92 |
| CBQ-Mg-6 | 8.7 ± 0.42 | 0.0 ± 0.00 |
| CBQ-Ni-24 | 21.2 ± 0.58 | 0.0 ± 0.00 |
| CBQ-Ni-32 | 5.9 ± 0.34 | 0.0 ± 0.00 |
| CBQ-OSS-4 | 8.9 ± 0.30 | 14.3 ± 2.38 |
| CBQ-Plat-3 | 20.4 ± 1.52 | 0.0 ± 0.00 |
| CBQ-Plat-4 | 24.2 ± 1.43 | 0.0 ± 0.00 |
| CBQ-SFe-5 | 4.0 ± 0.11 | 0.0 ± 0.00 |
| CBQ-Wni-21 | 28.3 ± 1.55 | 0.0 ± 0.00 |
| CBQ-RS-3 | 4.7 ± 0.19 | 0.0 ± 0.00 |
| CBQ-A-2 | 0.0 ± 0.00 | 0.0 ± 0.00 |
| CBQ-A-9 | 0.0 ± 0.00 | 52.7 ± 2.98 |
| CBQ-A-17 | 9.7 ± 0.33 | 32.6 ± 2.30 |
| CBQ-Amb-3 | 0.0 ± 0.00 | 0.0 ± 0.00 |
| CBQ-B-1 | 0.0 ± 0.00 | 35.0 ± 1.73 |
| CBQ-B-41 | 0.0 ± 0.00 | 21.5 ± 0.63 |
| CBQ-B-44 | 0.0 ± 0.00 | 41.5 ± 0.43 |
| CBQ-Be-29 | 0.0 ± 0.00 | 0.0 ± 0.00 |
| CBQ-Be-36 | 0.0 ± 0.00 | 0.0 ± 0.00 |
| CBQ-C-5 | 0.0 ± 0.00 | 5.6 ± 0.47 |
| CBQ-C-7 | 0.0 ± 0.00 | 17.8 ± 1.04 |
| CBQ-CB-6 | 17.8 ± 1.78 | 0.0 ± 0.00 |
| CBQ-CD-12 | 0.0 ± 0.00 | 0.0 ± 0.00 |
| CBQ-CD-19 | 3.4 ± 0.32 | 0.0 ± 0.00 |
| CBQ-CD-21 | 38.2 ± 1.26 | 0.0 ± 0.00 |
| CBQ-CD-23 | 26.6 ± 1.56 | 0.0 ± 0.00 |
| CBQ-CD-25 | 3.5 ± 0.36 | 0.0 ± 0.00 |
| CBQ-Cy-5 | 0.0 ± 0.00 | 0.0 ± 0.00 |
| CBQ-CYM-2 | 0.0 ± 0.00 | 0.0 ± 0.00 |
| CBQ-E-5 | 0.0 ± 0.00 | 0.0 ± 0.00 |
| CBQ-EA-29 | 17.7 ± 0.31 | 0.0 ± 0.00 |
| CBQ-EBa-1 | 0.0 ± 0.00 | 0.0 ± 0.00 |
| CBQ-EB-5 | 0.0 ± 0.00 | 0.0 ± 0.00 |
| CBQ-EBa-22 | 0.0 ± 0.00 | 44.3 ± 1.40 |
| CBQ-EBe-3 | 15.0 ± 0.12 | 0.0 ± 0.00 |
| CBQ-EBe-15 | 0.0 ± 0.00 | 0.0 ± 0.00 |
| CBQ-EBe-16 | 0.0 ± 0.00 | 0.0 ± 0.00 |
| CBQ-EBe-19 | 16.1 ± 0.49 | 0.0 ± 0.00 |
| CBQ-EBe-20 | 0.0 ± 0.00 | 0.0 ± 0.00 |
| CBQ-EC-5 | 20.0 ± 0.78 | 53.2 ± 0.98 |
| HSD0.05 | 6.7 | 8.5 |
| Actinobacterial Strain | Chitinolytic Halo (mm) a | Cellulolytic Halo (mm) b | Proteolytic Halo (mm) c |
|---|---|---|---|
| CBQ-B-8 | 32.8 ± 0.96 ab | 90.0 ± 0.41 a | 41.3 ± 0.48 abcd |
| CBQ-CB-3 | 0.0 ± 0.0 c | 49.3 ± 0.48 ab | 0.0 ± 0.0 e |
| CBQ-CB-14 | 32.5 ± 2.65 ab | 90.0 ± 0.41 a | 50.8 ± 2.53 abc |
| CBQ-CD-24 | 25.3 ± 0.96 b | 63.0 ± 2.38 ab | 34.5 ± 0.50 abcd |
| CBQ-EA-2 | 34.0 ± 1.41 a | 86.3 ± 0.48 ab | 44.8 ± 1.65 abcd |
| CBQ-EA-3 | 31.3 ± 0.96 ab | 36.3 ± 0.75 b | 31.8 ± 0.75 bcd |
| CBQ-CB-4 | 0.0 ± 0.0 c | 86.3 ± 0.48 ab | 0.0 ± 0.0 e |
| CBQ-EA-12 | 31.3 ± 3.20 ab | 80.0 ± 0.71 ab | 51.5 ± 1.50 a |
| CBQ-EBa-5 | 33.5 ± 1.91 a | 85.3 ± 1.18 ab | 42.3 ± 0.25 abcd |
| CBQ-EB-27 | 0.0 ± 0.0 c | 0.0 ± 0.0 c | 0.0 ± 0.0 e |
| CBQ-EBa-21 | 29.8 ± 1.26 ab | 68.5 ± 1.19 ab | 47.8 ± 1.4 abc |
| CBQ-EC-3 | 0.0 ± 0.0 c | 40.0 ± 0.71 ab | 0.0 ± 0.0 e |
| CBQ-EC-18 | 29.3 ± 0.96 ab | 0.0 ± 0.0 c | 0.0 ± 0.0 e |
| CBQ-ECa-24 | 0.0 ± 0.0 c | 90.0 ± 0.41 a | 27.0 ± 0.71 d |
| CBQ-ESFe-4 | 24.8 ± 0.50 b | 82.3 ± 2.59 ab | 0.0 ± 0.0 e |
| CBQ-ESFe-5 | 0.0 ± 0.0 c | 88.8 ± 0.75 ab | 41.3 ± 2.39 abcd |
| CBQ-ESFe-10 | 31.3 ± 0.96 ab | 81.8 ± 1.80 ab | 0.0 ± 0.0 e |
| CBQ-ESFe-11 | 32.3 ±2.90 ab | 84.5 ± 1.55 ab | 0.0 ± 0.0 e |
| CBQ-ESFe-12 | 29.0 ± 1.41 ab | 90.0 ± 0.41 a | 49.0 ± 0.71 ab |
| CBQ-J-4 | 27.0 ± 1.41 ab | 45.0 ± 1.41 ab | 27.3 ± 0.48 d |
| CBQ-Mg-6 | 0.0 ± 0.0 c | 62.0 ± 0.71 ab | 44.8 ± 0.48 abcd |
| CBQ-Ni-24 | 27.3 ± 0.96 ab | 88.8 ± 0.75 ab | 31.8 ± 025 cd |
| CBQ-Ni-32 | 29.8 ± 0.50 ab | 90.0 ± 0.41 a | 37.3 ± 0.48 abcd |
| CBQ-OSS-3 | 33.0 ± 4.8 ab | 67.0 ± 0.71 ab | 39.3 ± 0.48 abcd |
| CBQ-OSS-4 | 0.0 ± 0.0 c | 0.0 ± 0.0 c | 44.0 ± 0.71 abcd |
| CBQ-Plat-2 | 29.8 ± 0.50 ab | 90.0 ± 0.41 a | 44.3 ± 0.75 abcd |
| CBQ-Plat-3 | 0.0 ± 0.0 c | 90.0 ± 0.41 a | 32.8 ± 0.25 abcd |
| CBQ-Plat-4 | 31.3 ± 0.96 ab | 90.0 ± 0.41 a | 33.5 ± 0.50 abcd |
| CBQ-SFe-5 | 28.3 ± 3.36 ab | 47.3 ± 0.75 ab | 0.0 ± 0.0 e |
| CBQ-Wni-21 | 0.0 ± 0.0 c | 42.3 ± 0.48 ab | 36.5 ± 0.95 abcd |
| CBQ-WP-14 | 29.8 ± 0.50 ab | 90.0 ± 0.41 a | 44.0 ± 0.71 abc |
| Actinobacterial Strain Code | Gram Stain a | Aerial Mycelium b | Color | Shape | Elevation | Edge | Consistency | Pigment |
|---|---|---|---|---|---|---|---|---|
| CBQ-B-8 | + | + | White | Circular | Convex | Full | Hard | Yellow |
| CBQ-CB-14 | + | + | White | Circular | Convex | Full | Hard | Yellow |
| CBQ-CD-24 | + | + | White | Irregular | Convex | Whole | Hard | Beige |
| CBQ-EA-2 | + | + | White | Circular | Convex | Lobed | Hard | Yellow |
| CBQ-EA-12 | + | + | White | Circular | Pulvini | Whole | Hard | Brown |
| CBQ-EBa-5 | + | + | Yellow | Irregular | Convex | Lobular | Hard | Yellow |
| CBQ-EBa-21 | + | + | White | Irregular | Pulvini | Whole | Hard | Orange |
| CBQ-ESFe-4 | + | + | Yellow | Circular | Convex | Lobed | Hard | Beige |
| CBQ-J-4 | + | + | White | Circular | Convex | Whole | Hard | Beige |
| CBQ-OSS-3 | + | + | Yellow | Irregular | Convex | Lobular | Hard | Yellow |
| CBQ-Plat-2 | + | + | White | Circular | Convex | Whole | Hard | Yellow |
| Biochemical Parameters * | Actinobacterial Strain Code | ||||||||||
|---|---|---|---|---|---|---|---|---|---|---|---|
| CBQ-B-8 | CBQ-CB-14 | CBQ-CD-24 | CBQ-EA-2 | CBQ-EA-12 | CBQ-EBa-5 | CBQ-EBa-21 | CBQ-ESFe-4 | CBQ-J-4 | CBQ-OSS-3 | CBQ-Plat-2 | |
| Catalase production | + | + | + | + | + | + | + | + | + | + | + |
| Lactose Fermentation | + | + | + | + | - | - | - | + | - | + | - |
| Glucose Fermentation | + | + | + | + | + | D | - | - | + | D | + |
| Mannitol Fermentation | + | + | - | + | - | + | - | + | - | - | - |
| Dextrose Fermentation | - | - | + | + | D | - | D | + | - | - | + |
| Fructose Fermentation | + | + | + | + | + | + | + | + | - | - | + |
| Maltose Fermentation | + | + | + | + | + | + | + | D | + | + | - |
| Sucrose Fermentation | + | + | + | + | + | + | + | D | + | - | - |
| Xylose Fermentation | + | + | - | + | + | - | + | + | - | + | + |
| Raffinose Fermentation | + | + | + | D | - | - | + | + | + | + | D |
| Casein Hydrolysis | - | - | - | + | - | + | - | - | + | + | - |
| Citrate Utilization | + | + | + | + | + | + | + | + | + | + | + |
| Urea Hydrolysis | + | + | + | + | + | + | + | + | + | + | + |
| Nitrate reduction | + | + | + | + | + | + | + | + | + | + | + |
| Indole production | - | - | - | - | - | - | - | - | - | - | - |
| Methyl red | + | + | - | + | - | + | + | - | - | - | + |
| Voges Proskauer | - | - | - | - | - | - | - | - | - | - | - |
| Gelatin hydrolysis | + | + | + | + | - | + | + | - | + | + | + |
| Starch hydrolysis | + | + | + | + | + | + | + | + | + | - | - |
| Species | Isolate | Genbank Accession a | Blast Accession b | Query Length | Gaps c | Identities d | Maximum Identity (%) |
|---|---|---|---|---|---|---|---|
| Streptomyces sp. | CBQ-EA-2 | OM417233 | MT540570 | 1437 | 3/1390 | 1386/1390 | 99.71 |
| Streptomices sp. | CBQ-B-8 | OM417234 | EU263063 | 1491 | 1/1491 | 1490/1491 | 99.93 |
| Strain * | Isolation Substrate | Origin (Location, State) | Year of Collection |
|---|---|---|---|
| CBQ-RS-3 | Sediment | River Seibabo, Villa Clara | 2007 |
| CBQ-A-2 | Rhizosphere | Arco Iris, V. Clara | 2007 |
| CBQ-EA-2 a–c | Endophytic, stem of Mosiera bullata | Arco Iris, V. Clara | 2008 |
| CBQ-B-8 a–c | Rhizosphere, Carbonated brown | Botanical Garden UCLV, V. Clara | 2008 |
| CBQ-J-4 b,c | Rhizosphere Ferrallitic red | River Seco, Jibacoa, Manicarargua. V. Clara | 2008 |
| CBQ-A-9 | Rhizosphere | Arco Iris, V. Clara | 2008 |
| CBQ-A-17 | Rhizosphere | Arco Iris, V. Clara | 2008 |
| CBQ-C-5 | Rhizosphere | Cienfuegos | 2008 |
| CBQ-C-7 | Rhizosphere | Cienfuegos | 2008 |
| CBQ-B-1 | Rhizosphere | Botanical GardenUCLV, V. Clara | 2008 |
| CBQ-E-5 | ‘Fangos de Elguea’ | Corralillo, V. Clara | 2009 |
| CBQ-B-41 | Rhizosphere | Botanical Garden UCLV, V. Clara | 2009 |
| CBQ-B-44 | Rhizosphere | Botanical Garden UCLV, V. Clara | 2009 |
| CBQ-Be-29 | Rhizosphere | Escambray, Bernal | 2010 |
| CBQ-EC-3 b | Endophytic | Coge Finca, Camajuaní, V. Clara | 2010 |
| CBQ-EC-5 | Endophytic, stem of Petiveria alliacea. | V. Clara | 2010 |
| CBQ-Be-36 | Rhizosphere | Escambray, Bernal | 2010 |
| CBQ-EBe-3 | Endophytic, root of Hibiscus elatus | Bernal, Herradura, Manicarargua, V. Clara | 2010 |
| CBQ-Cy-5 | Rhizosphere | Key I, V. Clara | 2010 |
| CBQ-CYM-2 | Rhizosphere | Salinas, V. Clara | 2010 |
| CBQ-EA-29 | Endophytic, stem | Arco Iris, V. Clara | 2011 |
| CBQ-EBa-1 | Endophytic, root | Banao, S. Spíritus | 2011 |
| CBQ-EB-5 | Endophytic | Botanical Garden UCLV, V. Clara | 2011 |
| CBQ-EBa-22 | Endophytic, stem | Banao, S. Spíritus | 2011 |
| CBQ-EBe-15 | Endophytic, root | Planta Escambray, Bernal | 2011 |
| CBQ-EBe-16 | Endophytic, root | Planta Escambray, Bernal | 2011 |
| CBQ-EBe-20 | Endophytic, root | Planta Escambray, Bernal | 2011 |
| CBQ-EA-3 b | Endophytic | Arco Iris. V. Clara | 2011 |
| CBQ-EB-27 b | Endophytic, Stem | Jandín Botánico UCLV, V. Clara | 2011 |
| CBQ-EA-12 a,b | Endophytic, leaf of Mosiera bullata, | Arco Iris. V. Clara | 2011 |
| CBQ-EC-18 b | Endophytic, stem of Petiveria alliacea. | Coge Finca, Camajuaní, V. Clara | 2011 |
| CBQ-ECa-24 b | Endophytic, root | Caguanes, S. Spíritus | 2011 |
| CBQ-EBa-5 a,b | Endophytic, root | Banao. S. Spíritus | 2011 |
| CBQ-EBa-21 a,b | Endophytic, root of Piper aducum | Banao. S. Spíritus | 2011 |
| CBQ-Ni-24 b | Endophytic, stem | Nicho, V. Clara | 2011 |
| CBQ-Ni-32 b | Endophytic, stem | Nicho, V. Clara | 2011 |
| CBQ-ESFe-12 b | Endophytic, stem of Fleurya cuneata, | Loma Sta Fé, V. Clara | 2012 |
| CBQ-ESFe-5 b | Endophytic, stem of Fleurya cuneata, | Loma Sta Fé, V Clara | 2012 |
| CBQ-ESFe-10 b | Endophytic, stem of Fleurya cuneata, | Loma Sta Fé, V. Clara | 2012 |
| CBQ-ESFe-11 b | Endophytic, stem of Fleurya cuneata, | Loma Sta Fé, V. Clara | 2012 |
| CBQ-WP-14 b | Sediment, Clarias batrachus, | V. Clara | 2012 |
| CBQ-ESFe-4 a,b | Endophytic, leaf of Piper aduncum | Loma Santa Fé. V. Clara | 2012 |
| CBQ-Wni-21 b | Sediment | River Nicho, V. Clara | 2012 |
| CBQ-Amb-3 | Endophytic, Stem of Cecropia adenopu, | V. Clara | 2013 |
| CBQ-CB-14 a,b | Sediment | Caves de Bellamar, Matanzas | 2013 |
| CBQ-OSS-4 b | Endophytic | Topes de Collantes, S. Spíritus | 2013 |
| CBQ-Plat-3 b | Endophytic, Stem of Comocladia platyphylla. | V. Clara | 2013 |
| CBQ-Plat-4 b | Endophytic, Root of Comocladia platyphylla, | V. Clara | 2013 |
| CBQ-CB-3 b | Sediment | Caves de Bellamar, Matanzas | 2013 |
| CBQ-Plat-2 a,b | Endophytic, stem of Comocladia platyphylla. | V. Clara | 2013 |
| CBQ-OSS-3 a,b | Endophytic, leaf of Ossanum | Topes de Collantes, S. Spíritus | 2013 |
| CBQ-CB-4 b | Sediment | Caves de Bellamar, Matanzas | 2013 |
| CBQ-CD-12 | Rhizosphere | Key Las Dunas, V. Clara | 2014 |
| CBQ-CD-19 | Rhizosphere | Key Las Dunas, V. Clara | 2014 |
| CBQ-CD-21 | Rhizosphere | Key Las Dunas, V. Clara | 2014 |
| CBQ-CD-23 | Rhizosphere | Key Las Dunas, V. Clara | 2014 |
| CBQ-CD-25 | Rhizosphere | Key Las Dunas, V. Clara | 2014 |
| CBQ-CD-24 a,b | Rhizosphere | Key Las Dunas. V. Clara | 2014 |
| CBQ-Mg-6 b | Endophytic, stem of Rhizophora mangle | Mégano, La Habana | 2014 |
| CBQ-SFe-5 b | Rhizosphere | Sta Fé, V. Clara | 2015 |
Publisher’s Note: MDPI stays neutral with regard to jurisdictional claims in published maps and institutional affiliations. |
© 2022 by the authors. Licensee MDPI, Basel, Switzerland. This article is an open access article distributed under the terms and conditions of the Creative Commons Attribution (CC BY) license (https://creativecommons.org/licenses/by/4.0/).
Share and Cite
Díaz-Díaz, M.; Bernal-Cabrera, A.; Trapero, A.; Medina-Marrero, R.; Sifontes-Rodríguez, S.; Cupull-Santana, R.D.; García-Bernal, M.; Agustí-Brisach, C. Characterization of Actinobacterial Strains as Potential Biocontrol Agents against Macrophomina phaseolina and Rhizoctonia solani, the Main Soil-Borne Pathogens of Phaseolus vulgaris in Cuba. Plants 2022, 11, 645. https://doi.org/10.3390/plants11050645
Díaz-Díaz M, Bernal-Cabrera A, Trapero A, Medina-Marrero R, Sifontes-Rodríguez S, Cupull-Santana RD, García-Bernal M, Agustí-Brisach C. Characterization of Actinobacterial Strains as Potential Biocontrol Agents against Macrophomina phaseolina and Rhizoctonia solani, the Main Soil-Borne Pathogens of Phaseolus vulgaris in Cuba. Plants. 2022; 11(5):645. https://doi.org/10.3390/plants11050645
Chicago/Turabian StyleDíaz-Díaz, Miriam, Alexander Bernal-Cabrera, Antonio Trapero, Ricardo Medina-Marrero, Sergio Sifontes-Rodríguez, René Dionisio Cupull-Santana, Milagro García-Bernal, and Carlos Agustí-Brisach. 2022. "Characterization of Actinobacterial Strains as Potential Biocontrol Agents against Macrophomina phaseolina and Rhizoctonia solani, the Main Soil-Borne Pathogens of Phaseolus vulgaris in Cuba" Plants 11, no. 5: 645. https://doi.org/10.3390/plants11050645
APA StyleDíaz-Díaz, M., Bernal-Cabrera, A., Trapero, A., Medina-Marrero, R., Sifontes-Rodríguez, S., Cupull-Santana, R. D., García-Bernal, M., & Agustí-Brisach, C. (2022). Characterization of Actinobacterial Strains as Potential Biocontrol Agents against Macrophomina phaseolina and Rhizoctonia solani, the Main Soil-Borne Pathogens of Phaseolus vulgaris in Cuba. Plants, 11(5), 645. https://doi.org/10.3390/plants11050645

